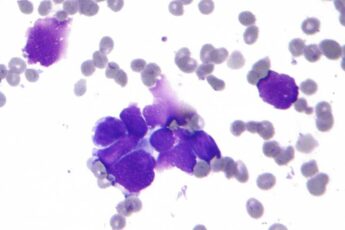

Test your knowledge and quick thinking with this fun and engaging quiz! Each question challenges you
Oncologist Yulia Shubina has listed types of cancer that can be passed down genetically. According to
In the coming hours, Moscow and nearby regions are expected to face heavy snowfall accompanied by strong
Do you consider yourself confident in Armenian spelling, vocabulary, and grammar? This test is a great
The United States has sent deported citizens to Armenia, Sputnik Armenia reports. According to the outlet
Do you consider yourself sharp-minded and quick at spotting the right answers? This test will challenge
In today’s world, where each of us is exposed to an endless flow of information, it is crucial to distinguish
“Veolia Water” company informs its customers and consumers that due to scheduled maintenance works, the
In recent years, a growing number of studies have focused on the impact of palm oil on human health.
From January 26 to February 1, three zodiac signs will feel a strong surge of luck and new opportunities.